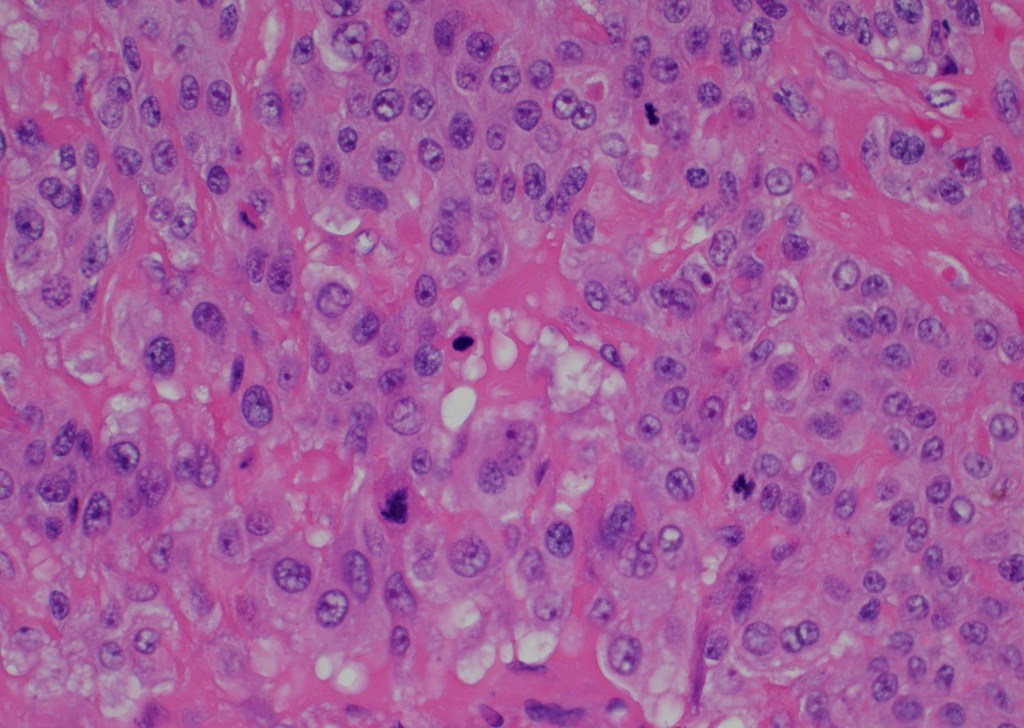

A 47-year-old woman with prolonged uterine bleeding and initial endometrial sampling with proliferative endometrium. Because of her prolonged uterine bleeding and leiomyomatous uterus she was taken to the operating room and hysterectomy was performed. Grossly, the uterus revealed multiple leiomyomas, but also a white-tan lesion in the lower uterine segment.
Microscopic examination: the lesion revealed nodular, expansile growth. The nodules were composed of epithelioid cells with abundant eosinophilic cytoplasm, frequent mitotic figures, and the background of necrosis. The nodules and the cells were embedded in the background of hyaline material (Figures 1-4). The cells were positive for GATA-3, alpha inhibin, cytokeratin, and negative for ER, PR, beta-hCG, p16, p53. The diagnosis of the epithelioid trophoblastic tumor (ETT) was rendered. Two years later she presented with new lung nodules. The biopsy showed a metastatic epithelioid trophoblastic tumor with the same immunophenotype. Immunohistochemistry for PD-L1 was positive.

Figure 1 
Figure 2 
Figure 3
Figure 4

The epithelioid trophoblastic tumor occurs in women of reproductive age, but can also occur also in peri/postmenopausal women. This is a rare trophoblastic malignancy that is usually seen after normal pregnancies, molar pregnancies, spontaneous or missed abortions. In our patient, the tumor occurred 15 years after her last pregnancy. Epithelioid trophoblastic tumors are usually treated with hysterectomy and the tumor is frequently resistant to chemotherapy. The tumors are metastatic in about 25% of the cases.
Grossly, the tumor is a distinct lesion or a mass (required for the diagnosis). Microscopically, the cells grow in a nodular pattern with pushing invasion into adjacent structures. The neoplastic cells are large with abundant cytoplasm, arranged in nests and sheets. The mitotic rate is variable, and it ranges from <10 per 10 high-power fields to brisk mitotic activity. High mitotic count is a poor prognostic sign. The background of eosinophilic hyaline-like material is frequently present. Many times, like in our example, extensive geographic necrosis is noted.
Calcifications, when seen, are somewhat unique for epithelioid trophoblastic tumors (usually not seen with placental site of trophoblastic tumor or choriocarcinoma). Clinically, these tumors can have a low level of beta-hCG; however, the increase in beta-hCG is never as high as in choriocarcinoma. The differential diagnosis includes placental site trophoblastic tumor (PSTT), placental site nodule (PSN), keratinizing squamous cell carcinoma of the cervix (SCC), and epithelium smooth muscle tumors (SMT) and PEComa’s, especially on the small biopsies.
The pathogenesis of this tumor is largely unknown, but it is hypothesized the tumor arises from “chorionic-type” intermediate trophoblast. In contrast to placental site trophoblastic tumor that arises from intermediate trophoblast at the implantation site and therefore, they have a slightly different immunohistochemical features.
Immunohistochemistry findings and the main differences in immunohistochemistry between epithelioid trophoblastic tumor and major differential categories are described in the table 1.
In conclusion, epithelioid trophoblastic tumor is a relatively rare tumor that usually occurs in the lower uterine segment and cervix. Given the location, it can be mistaken for squamous cell carcinoma of the cervix, epithelioid smooth muscle malignancies, and other trophoblastic tumors and lesions.
